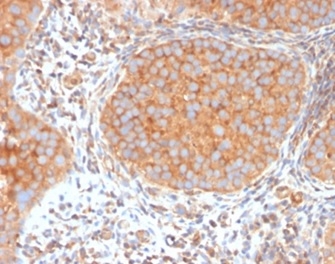

Formalin-fixed, paraffin-embedded human urothelial carcinoma stained with SERBP1 Mouse Monoclonal Antibody (SERBP1/3494).

Formalin-fixed, paraffin-embedded human kidney stained with SERBP1 Mouse Monoclonal Antibody (SERBP1/3494).

Western Blot Analysis of K562 and PC3 cell lysates using SERBP1 Mouse Monoclonal Antibody (SERBP1/3494).

SDS-PAGE Analysis Purified SERBP1 Mouse Monoclonal Antibody (SERBP1/3494). Confirmation of Purity and Integrity of Antibody.

Analysis of Protein Array containing more than 19,000 full-length human proteins using SERBP1 Mouse Monoclonal Antibody (SERBP1/3494). Z- and S- Score: The Z-score represents the strength of a signal that a monoclonal antibody (MAb) (in combination with a fluorescently-tagged anti-IgG secondary antibody) produces when binding to a particular protein on the HuProtTM array. Z-scores are described in units of standard deviations (SD's) above the mean value of all signals generated on that array. If targets on HuProtTM are arranged in descending order of the Z-score, the S-score is the difference (also in units of SD's) between the Z-score. S-score therefore represents the relative target specificity of a MAb to its intended target. A MAb is considered to specific to its intended target, if the MAb has an S-score of at least 2.5. For example, if a MAb binds to protein X with a Z-score of 43 and to protein Y with a Z-score of 14, then the S-score for the binding of that MAb to protein X is equal to 29.
SERBP1 is a membrane-associated protein that localizes to the nucleus, the perinuclear region of the cytoplasm and the plasma membrane. It is believed to play a role in the regulation of mRNA stability, as it specifically binds to the CRS (cyclic nucleotide-responsive sequence) motif of the PAI-1 mRNA and acts to stabilize the mRNA and regulate its expression. In addition, SERBP1 interacts with Mi2-伪 and may be involved in chromatin remodeling. It also interacts with PGRMC1 and participates in the transduction of Progesterone s antiapoptotic action in ovarian cell types. SERBP1 is overexpressed in ovarian cancer, suggesting a possible role in tumorigenesis and tumor metastasis.
There are no reviews yet.